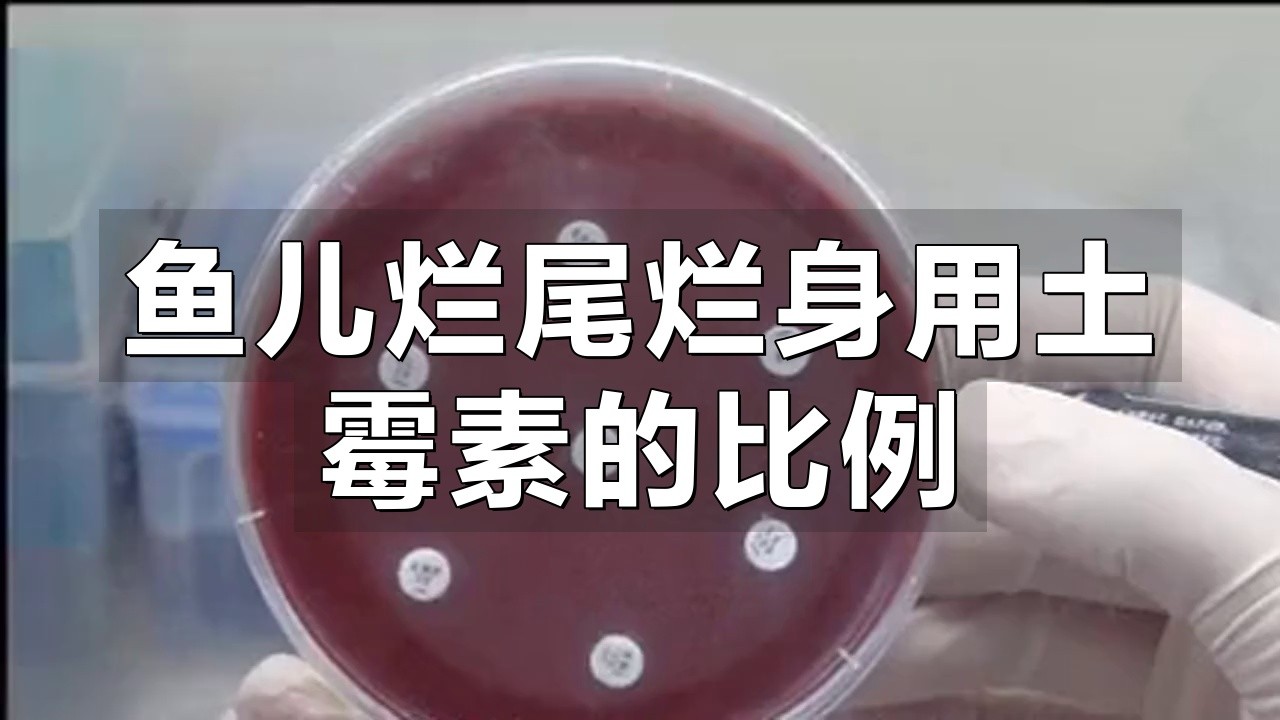
如何正確給龍魚使用土霉素？，土霉素的正確使用方法

如何正確給龍魚使用土霉素?,土霉素的正確使用方法
本文圍繞“如何正確給龍魚使用土霉素”展開闡述,土霉素可用于防治龍魚的一些細菌性疾病,但使用方法至關重要,在使用前,需精準診斷龍魚病癥,確認是由敏感菌引發且適用土霉素治療,要嚴格把控劑量,依據龍魚體型、水質狀況等因素合理調配,過量易致毒害,不足則療效欠佳,給藥方式多為溶于水中形成藥浴環境,期間密切觀察龍魚反應,若出現異常如浮頭、躁動等應立即調整或停止用藥,注意用藥時長,避免長期依賴產生耐藥性,用藥前后要做好水質監測與維護,保障水體穩定,以輔助藥物發揮最佳效果,助力龍魚恢復健康,確保整個治療過程安全、有效智能模式 回答完成調用工具:百度健康
以下是關于龍魚使用土霉素的詳細指南:
一、劑量計算
常規治療用量
- 每10升水需投放0.75克土霉素(約6片0.125克規格藥片),適用于細菌性感染初期治療12。
- 嚴重感染時可增至每10升水1克(8片0.125克規格藥片),但需密切觀察魚體反應45。
預防性用量
- 劑量減半,每10升水0.25克(2片0.125克規格藥片),適用于水質波動或新魚入缸時的預防16。
 02:57每日農業技術分享,魚用土霉素正確使用方法!肖玥棒棒噠
02:57每日農業技術分享,魚用土霉素正確使用方法!肖玥棒棒噠 01:48土霉素放魚缸比例多少合適小曹和大健
01:48土霉素放魚缸比例多少合適小曹和大健 01:43魚缸下土霉素用量臻造智控
01:43魚缸下土霉素用量臻造智控 02:01魚缸土霉素用量杜途紀行客
02:01魚缸土霉素用量杜途紀行客 02:34300升水魚缸土霉素用量筱筱筱周
02:34300升水魚缸土霉素用量筱筱筱周 01:45土霉素治魚病100升水加幾片vv居所札記展開
01:45土霉素治魚病100升水加幾片vv居所札記展開二、操作方法
溶解與投放
- 藥片需用溫水(≤35℃)完全溶解后均勻潑灑,避免直接投入未溶解藥片18。
- 若主缸用藥,需關閉過濾系統48小時以保護硝化細菌34。
環境調控
- 水溫需提升至26-30℃(腸炎治療建議32℃),并配合0.3%鹽浴增強藥效79。
- 每日換水1/3并補充等量藥物,持續2-3天為一個療程46。
三、注意事項
敏感魚種處理
- 無鱗魚(如龍魚)對藥物敏感,建議優先采用隔離藥浴,用量可減半59。
- 用藥期間停止喂食,避免污染水質及影響藥效36。
禁忌與風險
- 避免與黃粉、鹽類同時使用,可能引發毒性反應47。
- 一年內使用不超過2次,防止細菌耐藥性24。

四、替代方案
若龍魚對土霉素耐受性差,可考慮氟苯尼考或五倍子等中草藥輔助治療,但需嚴格遵循劑量指導710。
每日農業技術分享,魚用土霉素正確使用方法!肖玥棒棒噠土霉素放魚缸比例多少合適小曹和大健魚缸下土霉素用量臻造智控魚缸土霉素用量杜途紀行客300升水魚缸土霉素用量筱筱筱周土霉素治魚病100升水加幾片vv居所札記魚用土霉素正確使用方法凡上說養魚萬能藥是什么土霉素對魚有什么作用怎么使用嗶哩嗶哩觀賞魚常用藥---土霉素的正確使用辦法微博龍魚腸炎治療全攻略:土霉素與五號配合效果顯著北巷Lit魚兒爛尾爛身用土霉素的比例綠色使者編輯土霉素治療龍魚哪些疾病?
土霉素對龍魚有副作用嗎?
土霉素治療龍魚需要多久?
推薦閱讀:
文章版權聲明:本站文章來之全網,如有雷同請聯系站長微信xlyc002 ,轉載或復制請以超鏈接形式并注明出處。

發表評論